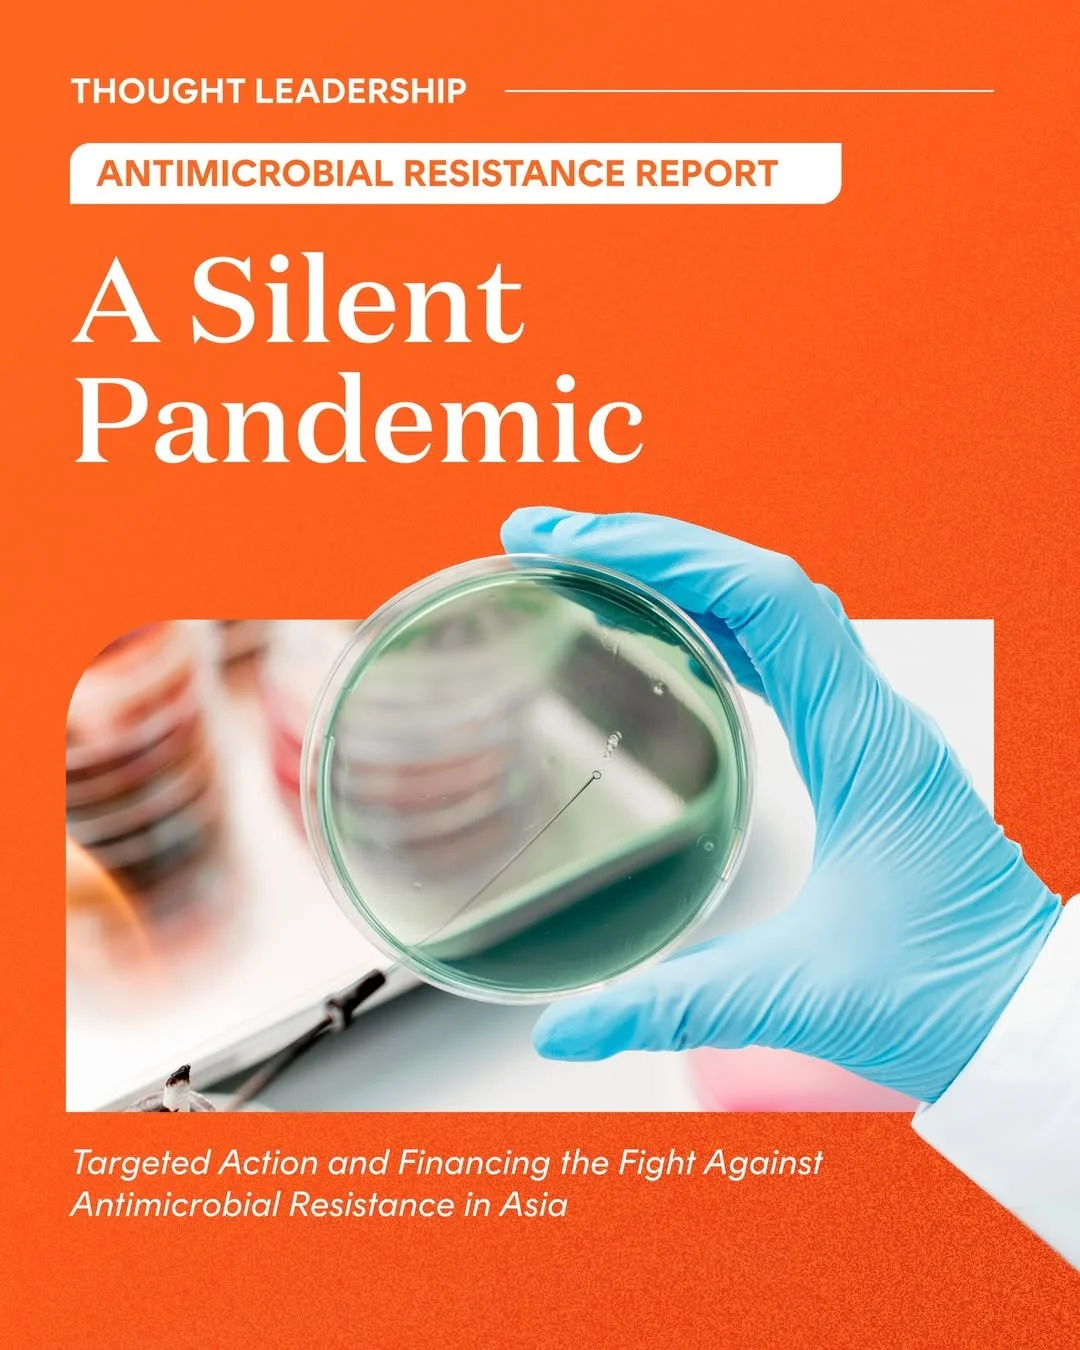
SnapInsta.to_495452384_1089879796506542_4281590737944201074_n.jpg

Temasek Trust
Social Media Copywriting by Ee Ming
Temasek Trust, established by Temasek Holdings, is a steward of philanthropic assets. It provides governance and financial oversight of endowments for an ecosystem of entities with the shared purpose of building better for every generation by protecting the planet, uplifting communities, connecting people, and advancing capabilities. In forging new pathways for philanthropy and impact investing with like-minded partners, Temasek Trust aims to promote catalytic philanthropy as a force for good.
Social media page